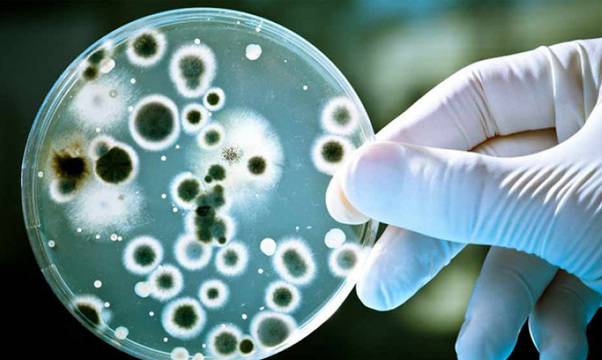
Причината за вечно запушения ви нос всъщност се крие в… червата! Не вярвате? Ето как да си помогнете сами:

Проблемът с вечно запушения нос може би се крие в червата ви! Не вярвате? Тогава прочетете редовете по-долу:
Имате ли затруднено дишане, защото носът ви постоянно е блокиран? Проблемът със синузита може да се крие в червата ви. Симптоми като кашлица, главоболие, треска и раздразнено гърло могат да са причинени от нещо толкова тривиално като храносмилателни проблеми .
Причинителят са зловредни гъбички, попаднали в тялото
За съжаление, злодеят бързо се разпространява в тялото, навлизайки в белите дробове и мозъка.
Това е така, защото токсините, произведени от него, навлизат в кръвта.
За да ви дадем по-ясна представа, ще цитираме проучване в клиниката Майо, изследвало 210 пациенти с хроничен синузит. Чрез проби от слуз от носната кухина било установено, че 96% от тях имат кандида.
Тоест, хроничният синузит ( гъбичен синузит ) не е нищо повече от реакция на организма, който страда от патогенни гъбички.
Някои хора, тъй като са по-чувствителни, в крайна сметка развиват по-големи проблеми, като кандидоза.
Други симптоми на гъбична инфекция в червата, в допълнение към казаното вече, са:
– болка в тялото
– лош дъх
– умора
– замаяност
– гадене
– акне
– вагинални заболявания
– кожни проблеми
– раздразнение
Някои храни стимулират растежа на гъбичките, например:
– рафинирана захар
– брашно
– бирена мая
– млечни продукти (с изключение на натурално кисело мляко)
– сладки напитки
– алкохолни напитки (главно бира)
В допълнение, някои лекарства, като антибиотици и самия стрес, също са вредни.
За щастие съществуват естествени алтернативи, които могат да се преборят с гъбичките.
Добавки и лекарства: потърсете добавки с каприлова киселина.
За тези, които не знаят, каприловата киселина се съдържа в кокосовото масло, така че го включете в диетата си!
Чесън, куркума и сода за хляб също помагат.
Трябва също да консумирате пробиотици и храни, богати на лактобацили, като натурално кисело мляко (за предпочитане домашно приготвено) и кефир, тъй като те могат да възстановят чревната бактериална флора.
– Диета: както казахме, избягвайте захарните храни и алкохолните напитки.
Елементарно нещо, което можем да направим у дома, са промивка на носа и устната лигавица:
Как да направим промивка на носа
Изсипете 1 чаена лъжичка сол и половин лъжичка сода за хляб в чаша гореща вода.
Разбъркайте добре и вдишайте.
Промивайте носа така два пъти на ден, докато инфекцията изчезне.
Ако ви боли гърлото, можете да изплакнете устата си с топла вода и сол.
Това помага за отваряне на дихателните пътища и борба с възпалението.
Най-ефективните етерични масла срещу гъбична инфекция, причиняваща горните симпотми, са евкалиптово, масло риган и масло от мащерка.
Използвайки тези методи, вашите дихателни проблеми със сигурност ще изчезнат или поне ще намалеят.